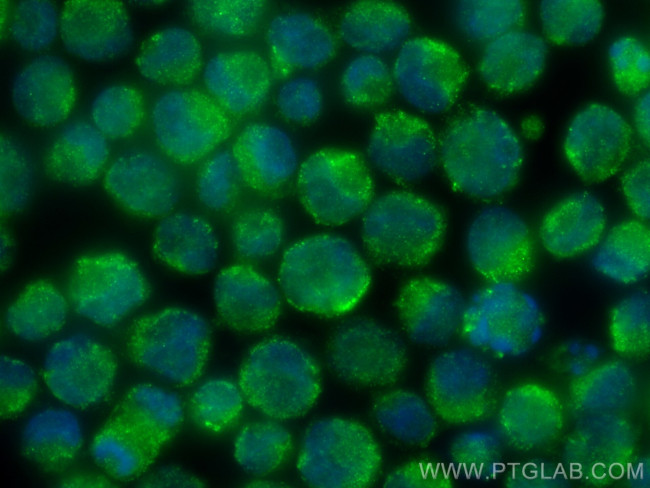
DYRK2 Antibody in Immunocytochemistry (ICC/IF)

Search
Proteintech
DYRK2 Polyclonal Antibody
{{$productOrderCtrl.translations['antibody.pdp.commerceCard.promotion.promotions']}}
{{$productOrderCtrl.translations['antibody.pdp.commerceCard.promotion.viewpromo']}}
{{$productOrderCtrl.translations['antibody.pdp.commerceCard.promotion.promocode']}}: {{promo.promoCode}} {{promo.promoTitle}} {{promo.promoDescription}}. {{$productOrderCtrl.translations['antibody.pdp.commerceCard.promotion.learnmore']}}
产品信息
21979-1-AP
种属反应
宿主/亚型
分类
类型
抗原
偶联物
形式
浓度
规格
纯化类型
保存液
内含物
保存条件
运输条件
产品详细信息
Sequence of this protein is as follows: MLTRKPSAAA PAAYPTGRGG DSAVRQLQAS PGLGAGATRS GVGTGPPSPI ALPPLRASNA AAAAHTIGGS KHTMNDHLHV GSHAHGQIQV QQLFEDNSNK RTVLTTQPNG LTTVGKTGLP VVPERQLDSI HRRQGSSTSL KSMEGMGKVK ATPMTPEQAM KQYMQKLTAF EHHEIFSYPE IYFLGLNAKK RQGMTGGPNN GGYDDDQGSY VQVPHDHVAY RYEVLKVIGK GSFGQVVKAY DHKVHQHVAL KMVRNEKRFH RQAAEEIRIL EHLRKQDKDN TMNVIHMLEN FTFRNHICMT
靶标信息
DYRK2 (also known as dual-specificity tyrosine-(Y)-phosphorylation regulated kinase 2) belongs to a family of protein kinases whose members are presumed to be involved in cellular growth and/or development and is defined by structural similarity of their kinase domains and their capability to autophosphorylate on tyrosine residues. DYRK2 expressed in E. coli demonstrated tyrosine autophosphorylation and catalyzed phosphorylation of histones H3 and H2B in vitro. DYRK2 also regulates p53 to induce apoptosis in response to DNA damage.
仅用于科研。不用于诊断过程。未经明确授权不得转售。
篇参考文献 (0)
生物信息学
蛋白别名: dual specificity tyrosine-(Y)-phosphorylation regulated kinase 2; Dual specificity tyrosine-phosphorylation-regulated kinase 2; Dyrk2; unnamed protein product
基因别名: 1810038L18Rik; DYRK2
UniProt ID: (Human) Q92630, (Mouse) Q5U4C9
Entrez Gene ID: (Human) 8445, (Mouse) 69181, (Rat) 314862